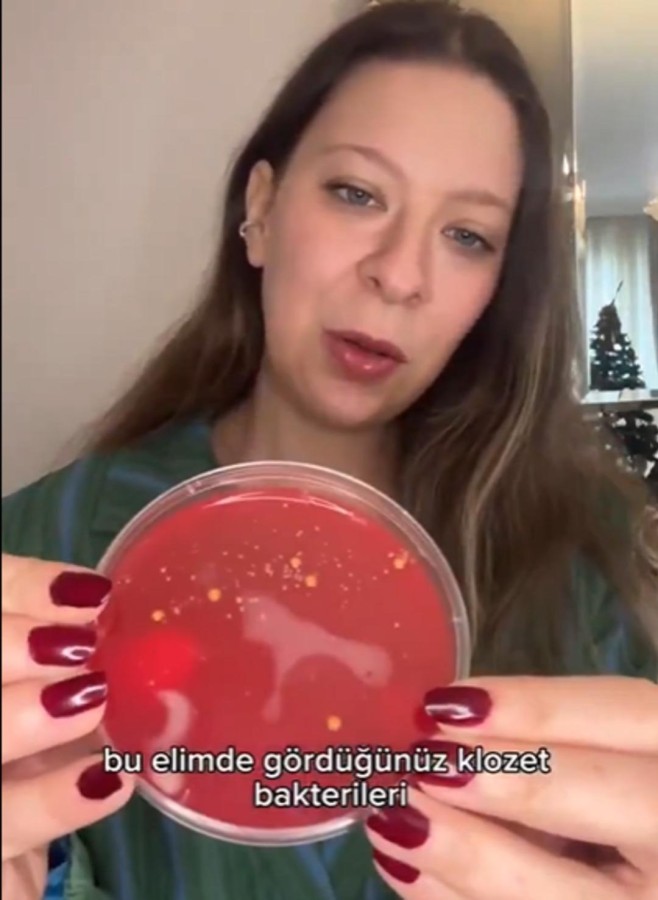

2024.12.30 09:51 Son Güncellenme: 2024.12.30 09:53 - GÜNDEM
Yastık kılıfı ve tuvalet arasında yapılan hijyen testi şoke etti! Dijital içerik üreticisi ve Genetik Mühendisi Dilara Sarı, bir hafta boyunca değiştirilmeden bırakılan yastık kılıfının klozetten 17.000 kat daha fazla bakteri barındırıp barındırmadığını test etti.
Genetik Mühendisi ve dijital içerik üreticisi Dilara Sarı, yaptığı son deneyle uyku sırasında yastık kılıfında biriken bakterilerin cilt sağlığı üzerindeki tehlikelerini gözler önüne serdi. Sarı, bir hafta boyunca değiştirilmeden bırakılan yastık kılıfının klozetten 17.000 kat daha fazla bakteri barındırdığını ortaya koyarak, bu unsurların hijyen açısından büyük bir tehdit oluşturduğunu vurguladı.

"SAÇ, CİLT VE TER GİBİ UNSURLAR YASTIĞA GEÇER"
Uzmanlar, yastık kılıfının sıklıkla değiştirilmesi gerektiğini belirtiyor. Cilt tipine ve kişisel hijyen alışkanlıklarına göre değişiklik gösterse de, genel tavsiye en az 2-3 günde bir kılıfın değiştirilmesidir. Güzellik Uzmanı Ezgi Şahin, "Uyku sırasında saç, cilt ve ter gibi unsurlar yastığa geçer ve bu durum bakterilerin hızla üremesine neden olur. Özellikle ciltte yağlanma sorunu yaşayan kişiler, yastık kılıflarını günlük olarak değiştirebilirler" dedi.
"YASTIK KILIFI, CİLDİMİZİN HER TÜRLÜ ATIĞINI TOPLAR"
Yastık kılıfında biriken bakterilerin temel nedeni, gece boyunca cildin ve saçın temas ettiği ter, yağ ve ölü deriden kaynaklanıyor. Bu unsurlar, bakterilerin hızla üremesini sağlıyor. Ezgi Şahin, "Yastık kılıfı, cildimizin her türlü atığını toplar. Cilt bakımı ve hijyen, sadece doğru ürünleri kullanmakla değil, aynı zamanda sağlıklı bir uyku ortamı yaratmakla da sağlanabilir" diyerek yastık kılıfının önemini vurguladı.

GECE BAKIM RUTİNİ VE CİLT SAĞLIĞI
Sağlıklı bir cilt için gece bakım rutini de son derece önemli. Güzellik Uzmanı Ezgi Şahin, uyku öncesinde cilt bakımının temel adımlarını şu şekilde sıralıyor: "Makyaj mutlaka temizlenmeli, ardından uygun temizleme ürünüyle cilt temizlenmeli ve sonrasında cilt tipine uygun serum ve nemlendirici uygulanmalıdır. Cilt uzmanlarıyla yapılan düzenli görüşmelerle doğru bakım ürünleri belirlenebilir."